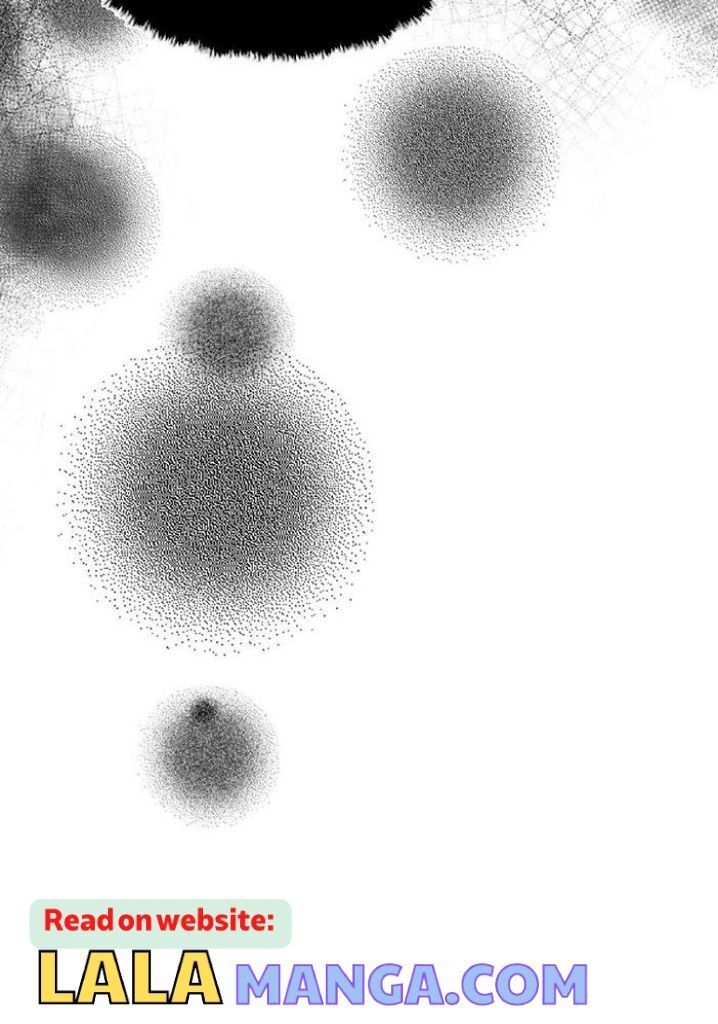

Read Manhua Demon Wants To Hug - 0094 Demon Wants To Hug ( Season 002 ) Chapter 45.3

Top
Read Manhwa DEAR. DOOR UNCENSORED version
0166 Chapter 163.5 Creator's Note
December 6, 2023
0165 Chapter 163 Special Episode 33 [THE END]_~
December 6, 2023
Read Manhwa Tentacle Recipe
0064 Chapter 060 _The End_
December 17, 2023
0063 Chapter 059
December 15, 2023
Read Manhwa Shutline
0082 Season 002 Finale
December 17, 2023
0081 Chapter 076
December 2, 2023
Read Manhwa Who’s your Daddy?
Side Story End
January 26, 2022
Side story 3
January 26, 2022
Read Manhwa Low Tide in Twilight「Official」
0113 Special Episode [END] Eleven Years Later
September 27, 2025
0112 Side Story 011
September 27, 2025
Read Manhwa It’s Not Like That
Chapter 45.2 side. 2 (the end)
June 26, 2022
Chapter 45.1 side. 1
June 26, 2022
Read Manhwa Jinx (Mingwa)
0117 Chapter 087
January 1, 2026
0116 Chapter 086
January 1, 2026
Maybe You Like
- Action (60)
- Adult (1028)
- Comedy (284)
- Doujinshi (216)
- Drama (732)
- Fantasy (214)
- hardcore (200)
- harem (4)
- Hentai (43)
- Historical (54)
- horror (14)
- Manga (431)
- Manhua (41)
- Manhwa (1278)
- Mature (847)
- Mystery (20)
- Omegaverse (145)
- One Shot (475)
- Psychological (99)
- Romance (659)
- School Life (85)
- Sci-fi (15)
- seinen (8)
- Shounen Ai (47)
- Slice of Life (88)
- Smut (1966)
- Supernatural (132)
- Tragedy (14)
- Uncensored (754)
- Webtoon (5)
- Yaoi (2224)
- Yuri [GL] (14)














